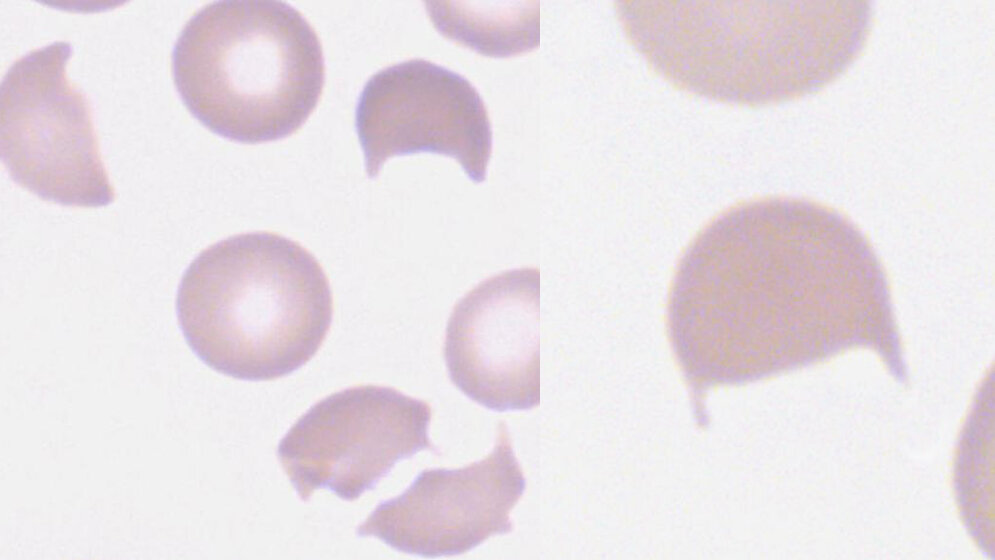
Fragmentozyten

Zusammenfassung
In Deutschland wird, um eine Verwechslung mit Erythrozytenanomalien anderer Genese zu vermeiden, nur die Helmform als Fragmentozyt gewertet. Der helmförmige Erythrozyt ist zytologisch dadurch charakterisiert, dass er aus einer intakten Konvexseite und einer beschädigten Konkavseite besteht. Bei blutgesunden Menschen finden sich <1‰ Fragmentozyten, d.h. in fünf Gesichtsfeldern der Vergrößerung Objektiv 100 (GF-100) wird höchstens ein Fragmentozyt angetroffen.
Entnommen aus MTA Dialog 02/2015
Dann nutzen Sie jetzt unser Probe-Abonnement mit 3 Ausgaben zum Kennenlernpreis von € 19,90.
Jetzt Abonnent werden